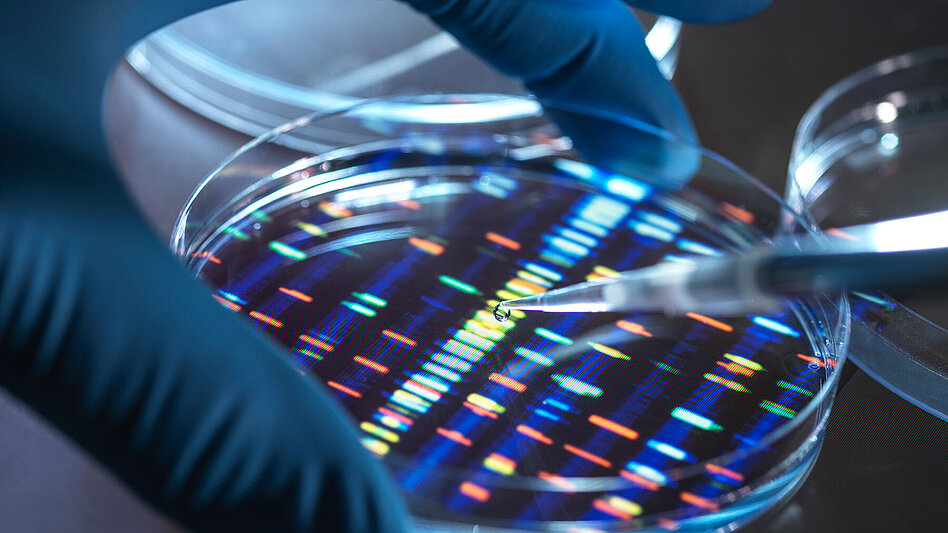

Personalisierte Medizin: Kenne deinen Krebs!
Jeder Mensch ist einzigartig – egal, ob mit oder ohne Krebs. Und so besonders, wie jede einzelne betroffene Person ist, so einzigartig sind auch die genetischen Merkmale eines Tumors. Darüber geben präzise genetische Tests Auskunft.
Wie du vielleicht selbst erfahren hast, kann Krebs jeden treffen. Die Betroffenen haben Familien, einen Freundeskreis und Leidenschaften, gehen Hobbys nach – und sind als Person einzigartig. Genauso individuell wie jede einzelne betroffene Person ist kann auch das genetische Profil ihres Tumors einzigartig sein. Und genau das kann der Schlüssel zu einer erfolgreichen Behandlung sein und einen großen Unterschied in der Krebstherapie ausmachen.
Erst in den letzten Jahrzehnten wurde es immer deutlicher, dass die gleiche Erkrankung von zwei Patientinnen oder Patienten nicht identisch ist. So kann das Profil des einen Tumors auf eine Therapie ansprechen, während eine andere hier nicht optimal wirkt oder Nebenwirkungen auslöst.1
Jede Krebserkrankung hat ein spezifisches Profil mit bestimmten genetischen Veränderungen.
Die personalisierte Medizin verändert, wie wir eine Krebserkrankung verstehen und behandeln. Statt einer „Therapie für alle“ rücken folgende Fragen in den Fokus: Welchen Tumor habe ich genau – und welche Behandlung passt dazu? Dieser Beitrag erklärt dir – Schritt für Schritt und gut verständlich – wie personalisierte Medizin in der Krebsbehandlung funktioniert, worauf du achten kannst und wie du gemeinsam mit deiner Ärztin oder deinem Arzt die für dich passende Therapieoption findest.
Was bedeutet personalisierte Medizin bei Krebs?
Personalisierte Medizin in der Onkologie (auch Präzisionsmedizin genannt) bedeutet, dass die Behandlung nicht nur nach dem Tumortyp oder dem betroffenen Organ gewählt wird. Stattdessen wird sie so ausgewählt, dass sie möglichst genau zu den Besonderheiten des einzelnen Tumors passt – also zu seinen molekularen und genetischen Tumoreigenschaften.
Molekulare Tumoreigenschaften beschreiben alle Veränderungen auf Ebene der Moleküle in der Tumorzelle: zum Beispiel bestimmte Eiweiße (Proteine), Rezeptoren auf der Zelloberfläche oder Signalwege, die das Wachstum der Tumorzellen steuern. Dieses „molekulare Tumorprofil“ zeigt, welche Strukturen und Funktionen im Tumor verändert sind und bietet Anhaltspunkte, wo eine gezielte Therapie angreifen kann.
Das genetische Tumorprofil ist ein Teil dieses molekularen Profils. Es beschreibt die Veränderungen im Erbgut der Tumorzellen, also in der DNA (Abkürzung aus dem Englischen für deoxyribonucleic acid). Dazu gehören zum Beispiel Mutationen, bei denen einzelne „Bausteine“ der DNA verändert, entfernt oder ausgetauscht sind. Solche genetischen Veränderungen können dazu führen, dass krankhaft veränderte Proteine entstehen, die das Wachstum und Überleben der Tumorzellen fördern.
Genetische Veränderungen sind damit häufig die Ursache der veränderten molekularen Eigenschaften des Tumors. Beides hängt also eng zusammen: Aus den genetischen Veränderungen ergibt sich das molekulare Tumorprofil – und genau dieses Zusammenspiel nutzt die personalisierte Medizin, um gezielt passende Therapien für die einzelne Patientin oder den einzelnen Patienten zu finden.
Je mehr Ärztinnen und Ärzte über diese Mutationen wissen, desto präziser können sie therapieren. Deshalb sollte bei bestimmten Krebsarten zu Beginn der Behandlung eine molekulare Testung des Tumorgewebes erfolgen.

Personalisierte Therapien setzen genau an den identifizierten Veränderungen an. Sie blockieren gezielt Signalwege oder Strukturen, die das Tumorwachstum fördern – oft bei gleichzeitig geringerer Belastung für gesundes Gewebe. Voraussetzung für eine solche Behandlung ist das Vorliegen eines passenden Biomarkers. Personalisierte Therapien können so eine wirksame Option für Menschen mit bestimmten Tumorprofilen darstellen.
Warum ist die personalisierte Medizin so wichtig?
Es gibt vier Haupttypen von Standard-Krebsbehandlungen: Operation, Strahlentherapie, Chemotherapie und Immuntherapie.1 Meistens wird eine Kombination dieser Verfahren eingesetzt, um auch resistente Tumoranteile zu bekämpfen. Neben den gewünschten Effekten, also dem Abtöten von Krebszellen und dem Schrumpfen des Tumors, schädigen diese Therapien jedoch oft auch gesunde Zellen.
Die verschiedenen Behandlungen wirken auf sehr unterschiedliche Weise: Bei einer Operation wird der Tumor ganz oder teilweise aus dem Körper entfernt. Die Strahlentherapie wirkt lokal, indem sie die Erbsubstanz (DNA) der Tumorzellen direkt an der betroffenen Stelle schädigt, sodass sich diese Zellen nicht weiter teilen können. Die Chemotherapie wirkt im gesamten Körper und greift vor allem schnell teilende Zellen an – dazu gehören Tumorzellen, aber auch gesunde Zellen, zum Beispiel in Haarwurzeln oder Schleimhäuten, was Nebenwirkungen erklären kann.
Die Immuntherapie verfolgt einen anderen Ansatz: Sie stärkt das körpereigene Abwehrsystem, damit es Krebszellen besser erkennen und bekämpfen kann. Bestimmte Immuntherapien richten sich gezielt gegen einen Tumormarker, wie z. B PD-L1. PD-L1 ist ein Molekül, das auf der Oberfläche von Tumorzellen oder Immunzellen sitzen kann und wie eine „Tarnkappe“ wirkt: Es bremst Abwehrzellen aus. Medikamente, die an PD-L1 oder seinen Partner PD-1 binden, blockieren diese Bremse. So können Immunzellen den Tumor wieder erkennen und angreifen. Ob eine solche Immuntherapie in Frage kommt, hängt daher auch davon ab, ob der Tumor diesen Marker trägt – ein typisches Beispiel dafür, wie personalisierte Medizin die Behandlung an die individuellen Eigenschaften des Tumors anpasst.
Hier setzt die personalisierte Medizin an – und mit ihr die molekulare Tumortestung. Die Tumortestung ist eine entscheidende Voraussetzung dafür, um die genetischen Veränderungen eines Tumors überhaupt erst sichtbar zu machen. Nur wenn bekannt ist, welche Mutationen oder andere Biomarker im Tumor vorliegen, kann eine passgenaue Krebstherapie ausgewählt werden. Je nachdem welche Ergebnisse die molekulare Tumortestung liefert, kann sich die passende Therapie dennoch aus Chemo-, Strahlen- oder Immuntherapie zusammensetzen.
Was sind Biomarker?
Biomarker sind messbare biologische Merkmale, die Aufschluss darüber geben können, welche Veränderungen im Tumor vorliegen und wie dieser auf bestimmte Therapien reagieren könnte. Solche Biomarker können beispielsweise genetische Mutationen, veränderte Eiweiße oder andere molekulare Strukturen sein.
Mit Hilfe der personalisierten Medizin können Therapien ausgewählt werden, die gezielt auf die individuellen genetischen Veränderungen eines Tumors abgestimmt sind. Damit lassen sich ineffektive Behandlungsversuche vermeiden, und es kann früher mit einer vielversprechenden Krebstherapie begonnen werden. Menschen mit Krebs gewinnen dadurch wertvolle Lebenszeit – und auch das Risiko für starke Nebenwirkungen kann dank personalisierter Medizin reduziert werden.3
Eine Analyse von rund 350 Studien zeigt: In der personalisierten Medizin sprechen fast fünfmal so viele Betroffene auf die Therapie an wie Menschen, die nicht mit einer personalisierten Therapie behandelt wurden.4
Wie werden genetische Veränderungen festgestellt?
In den vergangenen Jahren konnten Wissenschaftlerinnen und Wissenschaftler durch moderne Testverfahren immer mehr genetische Informationen über Tumore gewinnen. Diese helfen zu verstehen, warum Krebszellen wachsen und wie sie am besten bekämpft werden können.
Eine Methode ist das sogenannte „Comprehensive Genomic Profiling" (CGP) – ein umfassender genetischer Test, bei dem mit einer einzigen Analyse mehrere hundert relevante Mutationen in der DNA eines Tumors untersucht werden. So können personalisierte Therapien oder passende klinische Studien identifiziert werden, die auf das individuelle Tumorprofil abgestimmt sind.
Das hat verschiedene Vorteile: Es verhindert unnötige Therapien mit möglicherweise geringen Erfolgschancen und zeigt neue Behandlungswege auf. Auch die Teilnahme an klinischen Studien, die genau auf dein genetisches Profil abgestimmt sind, kann eine wertvolle Option sein.
Brustkrebs und der PIK3CA-Weg
Ein Beispiel für die Anwendung personalisierter Medizin ist der hormonrezeptorpositive, HER2-negative Brustkrebs. Bei etwa 40 Prozent dieser Betroffenen liegt eine Mutation im PIK3CA-Gen vor, das für einen wichtigen Signalweg im Zellwachstum verantwortlich ist (PI3K/AKT/mTOR). Wurde diese Mutation nachgewiesen, kann eine personalisierte Therapie mit einem PI3K-Inhibitor wie Alpelisib in Kombination mit einer Hormontherapie sinnvoll sein.5
Lungenkrebs: Molekulare Testung als Standard
Beim nicht-kleinzelligen Lungenkrebs (NSCLC) ist die molekulare Testung heute Standard. Hier wird beispielsweise nach Mutationen in den Genen EGFR, ALK oder KRAS gesucht. Je nach Ergebnis können personalisierte Therapien eingesetzt werden, die deutlich wirksamer und verträglicher sein können als klassische Chemotherapie. Auch sogenannte Liquid Biopsies – also Bluttests zur Analyse von Tumor-DNA – kommen zum Einsatz.
Seltene genetische Veränderungen: Neue Optionen
Auch bei seltenen genetischen Veränderungen wie NTRK oder ROS1 bietet personalisierte Medizin neue Chancen. Diese Mutationen können in verschiedenen Krebsarten vorkommen, darunter bestimmte Brustkrebs-Untergruppen, Sarkome oder Tumore der Lunge, Blase oder Speicheldrüsen. Früher waren personalisierte Therapien für diese Fälle kaum möglich. Heute können sie durch umfassende molekulare Analysen erkannt und gezielt behandelt werden.6,7
Digitalisierung und Zukunftsperspektiven
Die personalisierte Medizin entwickelt sich rasant weiter. Mit neuen digitalen Technologien lassen sich riesige Datenmengen aus der Diagnostik speichern, analysieren und miteinander vernetzen. So können individuelle Krankheitsverläufe besser verstanden, Therapien optimiert und Behandlungserfolge vorhergesagt werden. In Zukunft könnte dieses Wissen noch stärker genutzt werden, um Therapien genau auf Einzelpersonen zuzuschneiden und auch bei anderen Erkrankungen wie beispielsweise Alzheimer gezielter vorzugehen.
Was du tun kannst
Wenn bei dir eine Krebsdiagnose gestellt wurde, sprich dein Behandlungsteam auf mögliche molekulare Tests an. Stelle Fragen wie:
- Wurde mein Tumor genetisch analysiert?
- Gibt es Hinweise auf Treibermutationen?
- Welche personalisierten Therapien kommen für mich infrage?
- Gibt es klinische Studien, die zu meinem Tumorprofil passen?
Eine gut informierte Entscheidung kann helfen, den für dich passenden Behandlungsweg zu finden.

Erfahre noch mehr zum Thema „Personalisierte Medizin“ in unserem Kompaktwissen: Kenne deinen Krebs
Inhaltlich geprüft: M-DE-00030073
Quellen
¹ National Cancer Institute. Types of cancer treatment (2017), https://www.cancer.gov/about-cancer/treatment/types, zuletzt abgerufen am 21.11.2025
² Personalized Medicine Coalition. The personalized medicine report. Opportunity, challenges, and the future (2017), http://www.personalizedmedicinecoalition.org/Userfiles/PMC-Corporate/file/The_PM_Report.pdf, zuletzt abgerufen am 21.11.2025
³ Burney IA, Lakhtakia R. Precision medicine: Where have we reached and where are we headed? Sultan Qaboos Univ. Med.2017;17:e255–8.
⁴ Schwaederle M, Zhao M, Lee JJ, et al. Association of Biomarker-Based Treatment Strategies With Response Rates and Progression-Free Survival in Refractory Malignant Neoplasms: A Meta-analysis. JAMA Oncol.2016;2(11):1452–9.
⁵ https://www.aerzteblatt.de/archiv/mammakarzinom-alpelisib-verlaengert-progressionsfreies-ueberleben-bei-pik3ca-mutation-bae3e8ab-bcf0-4700-a363-48c9eb6247e9, zuletzt abgerufen am 21.11.2025
⁶ https://www.foundationmedicine.de/de/precision-medicine/precision-medicine.html, zuletzt abgerufen am 21.11.2025
⁷ https://www.dgho.de/publikationen/stellungnahmen/gute-aerztliche-praxis/ntrk-inhibitoren/tumor-agnostische-arzneimittel-20200113.pdf, zuletzt abgerufen am 21.11.2025